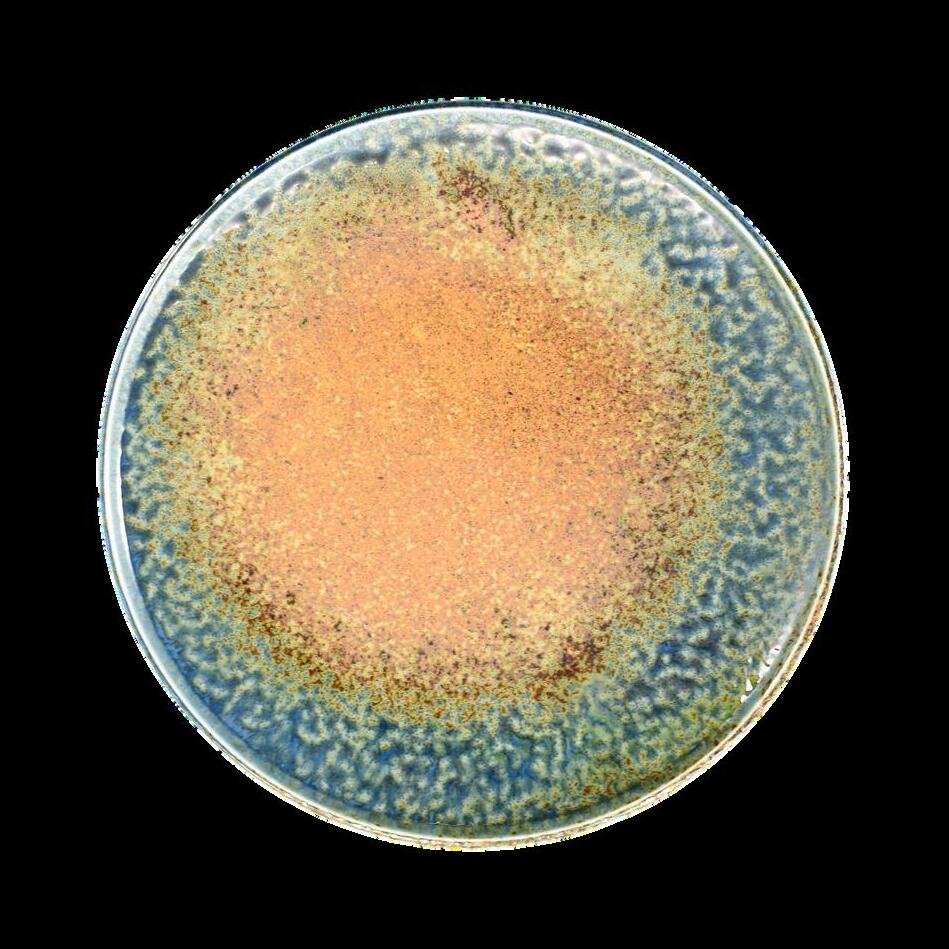

J a p a n t a b l e w a r e e d i t



J a p a n t a b l e w a r e e d i t


13 years ago, I was working at a Michelin-starred restaurant, cooking modern French dishes. I had access to some of the world’s best ingredients. At home, these were out of reach even from speciality supermarkets Souschef co uk was born from this frustration
Working my way through hundreds of cookbooks, I listed the ingredients that I couldn’t buy locally in a spreadsheet. Making a tally of the most frequently called-for

TheJapan-inspiredtable,directfromthemakers
Where can you find the sushi dishes and bowls you love at your local Japanese restaurant? The ramen bowls you’d find in a Tokyo ramen bar? And the cutest Bento boxes?
I know, because my small team and I have travelled back and forth to Japan, spending over a decade working with makers.
In Japan, setting the table is an art form. Colour, texture, and symmetry all shape our experience of food.
To inspire you to think about how to present your own food on these dishes, we ’ ve asked the endlessly-creative team at Angelina Restaurant in London to plate their Japanese-Italian menu using our collection. Read more overleaf.
Pay tribute to the craft of the maker in your own way one that suits your own table.
Whether you ’ re looking for new ways to serve dinners with friends or something to lift your breakfast ritual, I’m sure you’ll find something you love!
Happy cooking,
 Nicola, Sous Chef Founder
Nicola, Sous Chef Founder

Co-owner Laura and Sous Chef Khanh answer the question: What does Kaiseki mean to you?
LAURA: KaisekicomesfromKyoto
It’samulti-coursemealthattraditionally tookplacebeforeteaceremonies.Our menufollowsaveryclearstructure,with sevencourses(antipasti,chawanmushi, pane,crudo,pasta,binchotananddolci) Kaisekifitsreallywellwithwhatwedo.
Thestructurestaysthesame,butour menuischef’schoice.Italianand Japanesefoodsareveryingredientfocused androotedinseasonality.Wecurrently have13differentdishesonthemenu,and thesechangeallthetime.


KHANH:Kaisekiisacelebrationof seasonality.
Wehavedesignedthemenutoshowcase asmuchdiversityaspossibleintermsof colours,textures,andJapaneseandItalian ingredients.Alsoavarietyofdifferent stylesofeating frombitesizefingerfood andbreadtopastaandmains
Thatisourlooseframework,butitallows ustobereallycreativeandinnovative.We canbringinasmanydifferentingredients aswecanintermsofrotatingwiththe seasons
Italsoreflectsthediversitythatthereis acrosstheteaminthekitchenandthat existsinLondon.Wehaveaccesstoso muchamazingproduce Europeanand Japanese andwewanttobringasmuch ofthatin
It’sareflectionofwhatitistobeachefin London.Angelinaitselfissuperdiverse: werepresent24nationalities.
www.angelina.london @angelina.dalston

Whichdishshowcases Angelina’sethos?
KHANH:Ourpastacourse.Pastais obviouslyItalian,butwhatweputwiththe pasta(whetherit’sfilledorontop)canbe Japanese-inspired.
Ofallthepastas,myfavouritewasa triangolifilledwithtrufflericottaand toppedwithabuttermatchasaucewith pistachio.Soybutterwasrunningthrough.
ThecombinationofItalianpastamaking andmatchabutterwassomethingwhichI wouldneverhavethoughtof.Thefloral, herbalnotesofthematchaworkreallywell.










Blue Sakura Sake Set
Kaki Serving & Sushi Plate
Each sushi serving set comes with two sushi plates, two dipping bowls, and two pairs of chopsticks. Celebrate your homemade nigiri rolls, or simply plate your sushi delivery beautifully. Use the dipping bowls for soy sauce - or even pickles.











Mitsuo founded his family chopstick workshop in 1943, now in its third generation. Each set is handmade, and involves 10 to 15 steps of intricate craftsmanship, from shaping and priming to coating and colouring.


Olive&Mandarin WoodChopstick SetwithMatching Rests,18cm,£45

Persimmon&Plum WoodChopstick SetwithMatching Rests,18cm,£45

LancewoodGreen JapaneseLuxury ChopstickGiftSet, 23cm£27.99


GreenPepper,Aubergine&TomatoCeramic ChopstickRest,4cm,£5.99each

LancewoodBrown JapaneseLuxury ChopstickGiftSet, 23cm,£27.99

JapaneseLancewoodChopsticksfordifferent dishes.ChoosefromforFish;forDonburi&Udon; andforRamen,all23cm,£9.99each



MountFujiLancewood Chopsticks,£45





JapaneseRamenBowlSets,£45


Love ramen but thought it was too complicated to make? Sous Chef’s ramen bowl recipe kit is your shortcut to ramen mastery. Travel to Japan from your kitchen, with the bowls you’ll find in Tokyo’s ramen bars. Each bowl is crafted and hand-glazed in Mino Japan’s prized ceramic region. The iconic Sous Chef Ramen Set includes two bowls, two large bamboo ladles, plus our ramen recipes. With one that vegans will love!
The Sous Chef team cooking at the professional ramen school in Osaka, Japan - served in the Yukishino Ramen Bowls


Udon with deep fried sea leeks in Chouseki
These earthy tones and speckled textures are created by combining different quality glazes. Chouseki means tide, reflecting the fading, wave-like pattern

ChousekiRamen Bowl,£23.50
ChousekiBlueGold Plate,28.5cm £24.99


ChousekiNoodleBowl,17cm x8.5cm,£11.99



ChousekiShallowBowl,25cm, £19.99

ChousekiBlueGold SauceDish,9cmx6.5cm x2.5cmhigh,£5.99


ChousekiOblongPlate,21.5 x14cm,£14.99

Udon with deep fried sea leeks in Chouseki
 Clockwise from above:
Black Cat Plate, Sauce Dishes, Kaki Serving & Sushi Plate, Yukishino Sushi Set, Sakura Blossom Side Plate, Lancewood Brown Chopsticks, Sakura Blossom Sake Set, Blue Wave Small Plate, Chouseki Ramen Bowl, Sakura Blossom Square Plate, Karasuba-Iro Small Plate, Lancewood Navy Chopsticks
Clockwise from above:
Black Cat Plate, Sauce Dishes, Kaki Serving & Sushi Plate, Yukishino Sushi Set, Sakura Blossom Side Plate, Lancewood Brown Chopsticks, Sakura Blossom Sake Set, Blue Wave Small Plate, Chouseki Ramen Bowl, Sakura Blossom Square Plate, Karasuba-Iro Small Plate, Lancewood Navy Chopsticks

Make each dish unique
Curate a collection of your favourite plates in every size, colour and shape. Look forward to serving your dishes, as much as eating them.

5SeikouPorcelain AssortedFloralSide Plates,15cm,£169.99

ChousekiBlueGold Plate,28.5cm£24.99

MapleLeafRound DinnerPlate25.5cm£19

5SeikouPorcelainBirds onBranchGarnishPlates, 5.5cm,£94.99


Karasuba-IroSmallPlate, £8.99
ShimaSidePlate,22cm, £11.99


SakuraBlossomSide Plate,22.5cm,£10.99

SeikouPorcelainGreenPattern SidePlate,15cm,£34.99
SakuraBlossomSquare Plate,£8.99

This textured glaze depicts early spring. The duck-egg blue is reminiscent of the sky, with delicate cherry blossom (sakura) trees. Each piece has a deeper-coloured rim, matching the flower stems.

LargeSakuraDinner Plate,28.5cm,£27.99

SakuraServingPlatter
£27.99


SakuraBlossom SquarePlate,£8.99

Setof4SakuraBlossom Bowls,13cm,£39.99

SakuraRiceBowl £9.99

























 Dantsuki Jujuba Wood Bowl
Karasuba-Iro Matcha Bowl
Dantsuki Jujuba Wood Bowl
Karasuba-Iro Matcha Bowl







Spend
your






Incredibly cute

BlackCatJapaneseSide Plate,17.5cm,£17.99

BlackCatJapaneseBowl, 14cm,£9.99

IvoryCatSmallPlate,11cm,£10.99

GreenLuckyCatBowl, 14cm,£9.99

PinkLuckyCatRamen Bowl,21cm,£22.50

PinkLuckyCatBowl, 14cm,£9.99

BlueLuckyCatNoodle Bowl,15cm,£17.50











